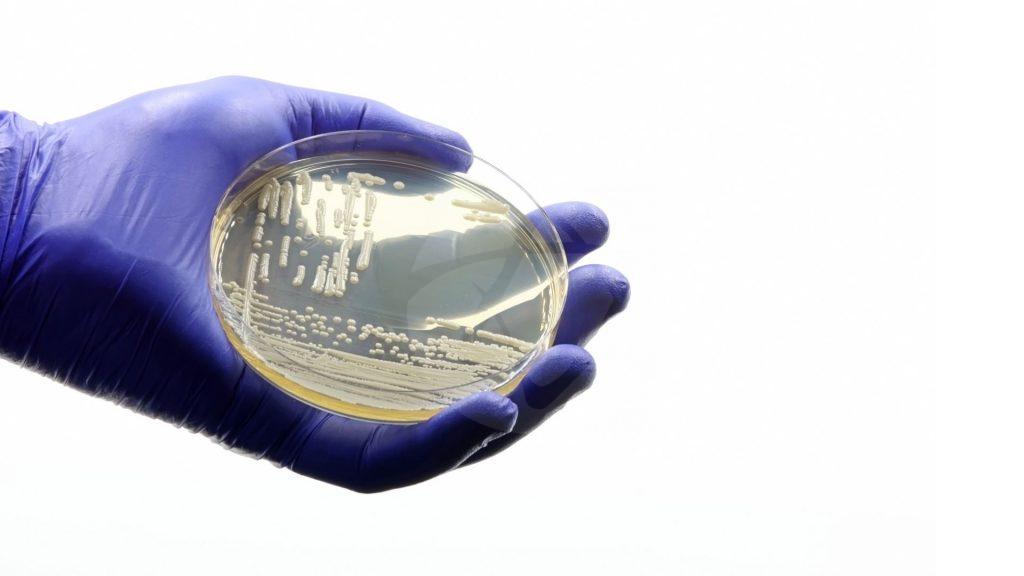

Notícias

Esta é uma reportagem exclusiva para veículos de comunicação e/ou jornalistas cadastrados. Para ter acesso, O processo é rápido e fácil.
Pesquisa do Reino Unido mostra que aparelhos podem ajudar a descobrir surgimento de sintomas característicos da doença até 7 anos antes da avaliação clínica.
Parkinson Leia mais
Esta é uma reportagem exclusiva para veículos de comunicação e/ou jornalistas cadastrados. Para ter acesso, O processo é rápido e fácil.
O método terapêutico é uma espécie de imunoterapia; tecnologia cria uma droga que 'ensina' o sistema imunológico a combater a doença.
Câncer Leia mais
Esta é uma reportagem exclusiva para veículos de comunicação e/ou jornalistas cadastrados. Para ter acesso, O processo é rápido e fácil.
Entre maio e junho deste ano, foram nove casos apenas em Pernambuco; São Paulo registrou o primeiro em um bebê prematuro de Campinas.
Superfungo Leia mais
Esta é uma reportagem exclusiva para veículos de comunicação e/ou jornalistas cadastrados. Para ter acesso, O processo é rápido e fácil.
Estudo do InCor mostra que doença causada pela exposição a agentes alergênicos ou irritantes tem controle difícil e impacta na qualidade de vida do trabalhador.
Asma Leia mais
Esta é uma reportagem exclusiva para veículos de comunicação e/ou jornalistas cadastrados. Para ter acesso, O processo é rápido e fácil.
Estudo inédito relata ganhos na qualidade de vida e alívio em sintomas como fadiga e dores musculares em pacientes que manifestaram a forma grave da doença.
Covid-19 Leia mais
Esta é uma reportagem exclusiva para veículos de comunicação e/ou jornalistas cadastrados. Para ter acesso, O processo é rápido e fácil.
Hipertensão e perda auditiva ocupam, respectivamente, o segundo e o terceiro lugar; estudo mostra que quase metade dos casos de perda cognitiva poderiam ser prevenidos.
Demência Leia mais
Esta é uma reportagem exclusiva para veículos de comunicação e/ou jornalistas cadastrados. Para ter acesso, O processo é rápido e fácil.
Pediatras alertam sobre a importância de observar sinais de desidratação; diarreia ainda é uma das principais causas de mortes de crianças menores de 5 anos.
Diarreia Leia mais
Esta é uma reportagem exclusiva para veículos de comunicação e/ou jornalistas cadastrados. Para ter acesso, O processo é rápido e fácil.
Pesquisa da Universidade de Nova York detalha ação de células-tronco ‘presas’ no folículo capilar e como influencia a capacidade de produção de pigmento no cabelo.
Células-tronco Leia mais
Esta é uma reportagem exclusiva para veículos de comunicação e/ou jornalistas cadastrados. Para ter acesso, O processo é rápido e fácil.
A infecção por objetos pode ocorrer, mas é mais rara. Entre as medidas preventivas, é importante manter bons hábitos de higiene, como lavar sempre as mãos.
Leia mais
Esta é uma reportagem exclusiva para veículos de comunicação e/ou jornalistas cadastrados. Para ter acesso, O processo é rápido e fácil.
Mudanças repentinas com a chegada da maternidade podem trazer consequências emocionais para a saúde da mulher; saiba o que esperar dessa fase.
Maternidade Leia mais